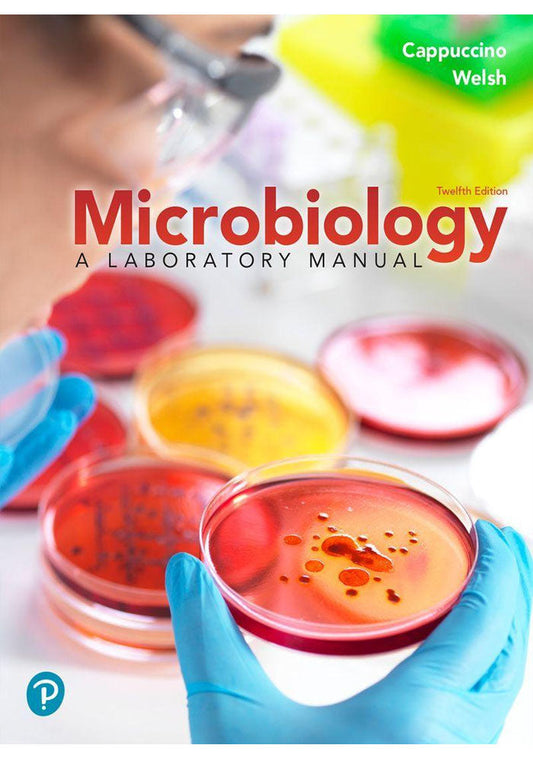
Microbiology: A Laboratory Manual 12th Edition

This loose-leaf, three-hole punched textbook that gives students the flexibility to take only what they need to class and add their own notes–all at an affordable price.
For all orders exceeding a value of 100USD shipping is offered for free.
Returns will be accepted for up to 10 days of Customer’s receipt or tracking number on unworn items. You, as a Customer, are obliged to inform us via email before you return the item.
Otherwise, standard shipping charges apply. Check out our delivery Terms & Conditions for more details.
Returns will be accepted for up to 10 days of Customer’s receipt or tracking number on unworn items. You, as a Customer, are obliged to inform us via email before you return the item, only in the case of:
– Received the wrong item.
– Item arrived not as expected (ie. damaged packaging).
– Item had defects.
– Over delivery time.
– The shipper does not allow the goods to be inspected before payment.
The returned product(s) must be in the original packaging, safety wrapped, undamaged and unworn. This means that the item(s) must be safely packed in a carton box for protection during transport, possibly the same carton used to ship to you as a customer.
People Also Bought
Here’s some of our most similar products people are buying. Click to discover trending style.